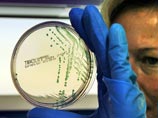

|
 |
 |
 |
| ||||||||||||
 |
Вокруг света
Первый случай смерти от кишечной инфекции зафиксирован во Франции
2:36PM Saturday, Jul 2, 2011
Первый случай гибели из-за вспышки кишечной инфекции зафиксирован во Франции, сообщил Департамент здравоохранения Бордо. Именно там были госпитализированы пациенты с признаками опасного заболевания. Позже один из них скончался в больнице, передает "Эхо Москвы" со ссылкой на France Press. Таким, образом количество смертельных случаев в результате заражения особо опасным штаммом E.сoli (кишечной палочки) в Европе перевалил за 50 человек. В Германии зафиксировано 48 смертей, по одному человеку умерло от инфекции в Швеции и США, а теперь и во Франции. По данным ВОЗ, в Германии после вспышки инфекции в начале мая пострадали более 3,9 тысячи человек, более 800 из них перенесли особо тяжелую форму болезни, которая сопровождается осложнениями, известными как гемолитический уремический синдром (HUS). Число новых случаев инфекции после пика, пришедшегося на 30 мая, стабильно снижается, успокаивают немецкие власти. Вспышка кишечной инфекции изначально была зафиксирована на севере Германии. Сначала предполагалось, что переносчиком опасных бактерий являются огурцы из Испании, но это предположение не подтвердилось. Затем специалисты заявили, что источником инфекции могла стать ферма в Нижней Саксонии, которая поставляет на рынки страны пророщенную сою и другие злаки, используемые для приготовления салатов и вторых блюд. В минувший четверг специалисты Европейского центра по профилактике и борьбе с заболеваниями (ECDC) заявили, что зараженные бактерией E. coli пророщенные семена могли быть ввезены в Европу из Египта в 2009-2010 годах.
По материалам NewsRu.com
Другие новости по теме
• В Грузии вынесли приговор российским "шпионам"…• Во Франции зафиксирована первая смерть от кишечной инфекции… • Жители Марокко проголосовали за конституционную реформу… • Супруга Арнольда Шварценеггера подала на развод… • Кейт Мосс вышла замуж за гитариста The Kills… • Из отеля Hilton в центре Лондона эвакуировали 1,5 тысячи человек… • Африканский союз отказался признать ордер на арест Каддафи… • На вечеринке в доме Алена Делона ранена девушка… • Компания BMW модернизировала техническую начинку "пятерок"… • В 2011 году Volvo планирует продать почти полмиллиона машин… • Лойкс заменил Копецки на Ралли Богемии в Чехии… • Князь Монако женился… • Команды Формулы-1 захотели проводить по две гонки в США… • Войска Каддафи отбили наступление повстанцев на Триполи… • В Грузии приняли закон о "нейтральных паспортах" для Абхазии… • Renault назвала спецсерии Clio и Twingo в честь гоночного трека…
|
| News Central Home | News Central Resources | Portal News Resources | Help | Login |